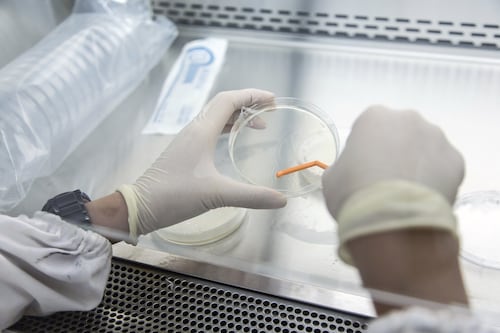
¿Qué sabemos sobre la misteriosa ‘enfermedad X’ que investigan médicos en el Congo?

gripe
Alerta en EU: Temporada de gripe deja 216 muertes infantiles, el peor saldo en 15 años
Las autoridades sanitarias de EU reportaron 216 muertes infantiles por gripe en la actual temporada, superando los registros del año anterior.
Gripe aviar: Diseñan vacuna con mayor protección que podría servir para combatir el virus
Investigadores están diseñado un método para aumentar la eficacia de la vacuna contra variantes gripales.
¿Qué sabemos sobre la misteriosa ‘enfermedad X’ que investigan médicos en el Congo?
Desde finales de octubre se han registrado más de 400 casos de la 'enfermedad X' que no está identificada
¿Tomas Next FWD para la gripe? Estas son las razones por las que tomarlo es peligroso
Aunque existen gran variedad de antigripales para aliviar los síntomas de enfermedades respiratorias, algunos pueden traer consecuencias negativas a la salud.
La gripe como ‘entrenadora’ para luchar contra el cáncer
De acuerdo con un estudio realizado en ratones, los que fueron infectados con gripe desarrollaron tumores de manera más lenta que los que no tuvieron la infección.
¿Antiflu-Des es malo para la salud? Experto explica los riesgos de tomar este medicamento
El epidemiólogo Diego Ramonfaur, investigador de la Cleveland Clinic Foundation, aconsejó no recetar este medicamento al público debido a sus efectos secundarios y a las sustancias activas que posee.
El amor y el desamor influyen para contraer gripe y otro virus; así es como sucede
El cortisol elevado por angustia vital y estrés crónico está asociado a una mayor susceptibilidad a diferentes enfermedades entre las que destacan las relacionadas con el sistema inmune y los virus.
¡Ponte el Cubrebocas! ¿Cuándo inicia la temporada de influenza 2023?
La temporada de influenza en México comienza en otoño y podría prolongarse hasta mayo, de acuerdo con los CDC.
Temporada invernal 2023: ¿Cuáles son los síntomas de la gripe y el COVID-19?
Estos son los síntomas de la gripe y del COVID-19; las autoridades sanitarias recomiendan realizarse una prueba para confirmar el diagnóstico.
¿Cómo ayuda el jengibre contra la gripe?
Si te duele la garganta y no dejas de toser, en tu cocina podrías encontrar un ingrediente que puede ayudarte contra varios síntomas del resfriado.